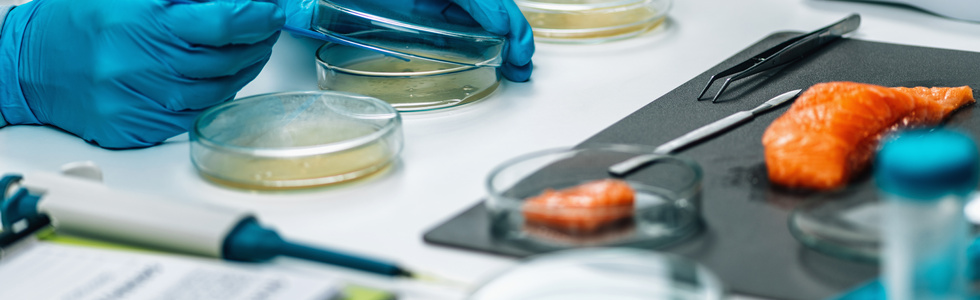
Allevamento, igiene, patologia delle specie acquatiche e controllo dei prodotti derivati

Allevamento, igiene, patologia delle specie acquatiche e controllo dei prodotti derivati
Scuola di specializzazione in Allevamento, igiene, patologia delle specie acquatiche e controllo dei prodotti derivati
La Scuola ha lo scopo di formare specialisti che abbiano maturato conoscenze teoriche, scientifiche e professionali nei campi della idrobiologia ed ecologia degli ambienti acquatici, del riconoscimento tassonomico delle principali specie acquatiche commercializzate, delle produzioni ittiche quali fonti alimentari per l’uomo, delle tecnologie degli allevamenti ittici e della pesca, delle patologie delle specie acquatiche e delle norme igieniche generali e particolari ai fini della tutela degli allevamenti e dell’ambiente, delle catene produttive per ottenere le migliori qualità di prodotto, degli approvvigionamenti annonari, mercati ed industrie dei prodotti e dei sottoprodotti ittici, dei controlli ispettivi ed igienico-sanitari dei prodotti della pesca e dell’acquacoltura destinati all’alimentazione umana, di tutte le pertinenti legislazioni.
La Scuola adotta una Politica per la Qualità che assicura l'erogazione delle attività formative con un approccio orientato a soddisfare le esigenze degli specializzandi, del personale docente e non docente, in un'ottica di innovazione e di miglioramento continuo, oltre al conseguimento di risultati di appropriatezza, efficacia ed efficienza nelle attività formative e assistenziali degli specializzandi, al fine di formare Specialisti di Area veterinaria in grado di esercitare al meglio la professione.
Nell'ottobre 2021 la Scuola ha aderito ad un progetto volto all'implementazione e alla certificazione del proprio sistema di gestione per la qualità, in conformità alla norma UNI EN ISO 9001:2015. Tale certificazione ha validità triennale ed è subordinata a procedure di audit annuale e ad un riesame completo dei requisiti alla scadenza.
Il 20 marzo 2023 la Scuola ha sostenuto l'audit di certificazione con TÜV AUSTRIA ITALIA Blu Solutions S.r.l. con esito positivo.
Certificato di conformità alla norma ISO 9001:2015 - Allevamento igiene, patologia delle specie acquatiche e controllo dei prodotti derivati ![]()
La Scuola rilascia il titolo di specialista in Allevamento, igiene, patologia delle specie acquatiche e controllo dei prodotti derivati.
Direttore: Francesco Quaglio
Email: francesco.quaglio@unipd.it
Referente per la qualità: Lucia Bizzotto
Email: lucia.bizzotto@unipd.it
Dipartimento di Biomedicina comparata e alimentazione
Segreteria Didattica
Viale dell'Università, 16 - 35020 Legnaro (PD)
Tel. 049 827 2587
Email: specializzazione.ittico@unipd.it; didattica.bca@unipd.it
Durata: 3 anni
Numero posti a statuto: 40
Requisiti per l'ammissione: l'ammissione alla Scuola di specializzazione in Allevamento, igiene, patologia delle specie acquatiche e controllo dei prodotti derivati è riservata a coloro che sono in possesso della laurea in Medicina veterinaria (ante D.M. 509/1999) o di una laurea specialistica a ciclo unico in Medicina veterinaria (ex D.M. 509/1999) della classe 47/S o di una laurea magistrale in Medicina veterinaria della classe LM-42 (ex D.M. 270/04).



